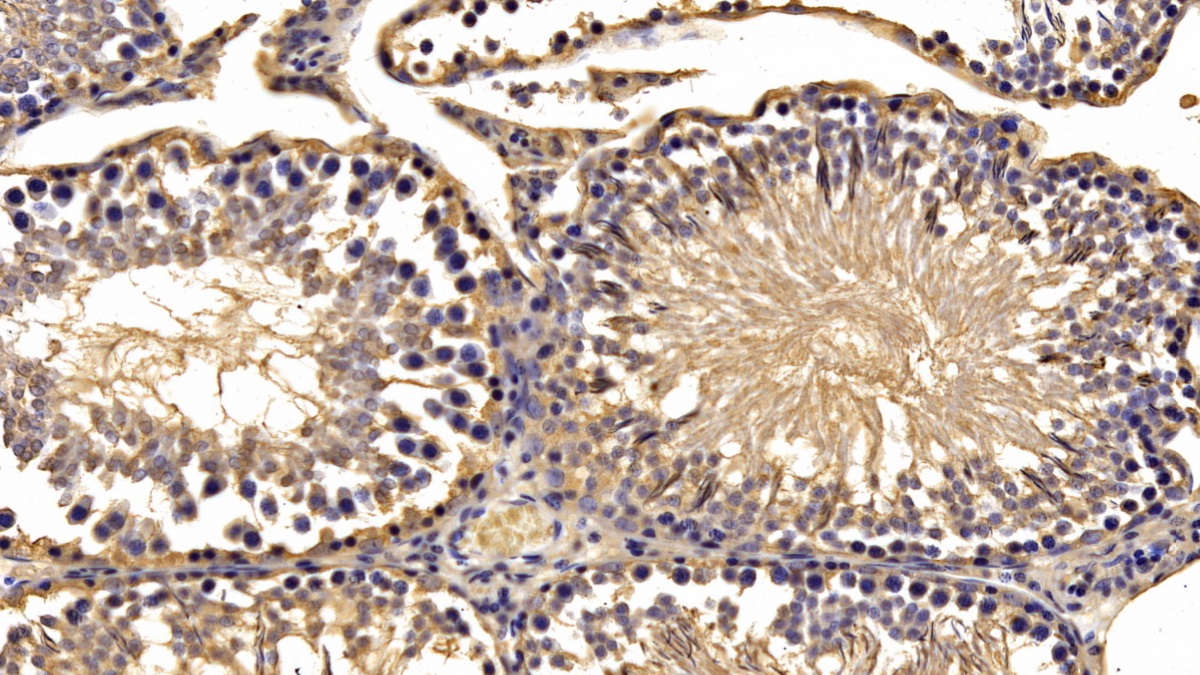

分泌型卷曲相关蛋白1(SFRP1)单克隆抗体
Monoclonal Antibody to Secreted Frizzled Related Protein 1 (SFRP1)
FRP1; FRP; FRP-1; FrzA; SARP2; Secreted apoptosis-related protein 2
- 编号MAF880Ra21
- 物种Rattus norvegicus (Rat,大鼠)相同的名称,不同的物种。
- 来源单抗制备
- 宿主小鼠
- 效价(克隆号)C2
- Ig亚型 IgG
- 纯化方式蛋白A + 蛋白G亲和纯化
- 标记物无标记物
- 免疫原-
- 缓冲液成份磷酸盐缓冲液(pH7.4, 含有 0.01% SKL, 1mM DTT, 5% Trehalose和Proclin300.)
- 性状液体
- 浓度1mg/mL
- 且适物种-
- 应用WB; IHC; ICC; IP.
如果抗体需用于流式细胞术,请参见流式抗体。 - 下载英文说明书 中文说明书
- 规格20µl100µl200µl1ml10ml
- 价格¥ 720¥ 1680¥ 2400¥ 6000¥ 24000
- 欲了解实际交易价格和更多情况,请与当地经销商联系!
特异性
该抗体是针对SFRP1的小鼠单克隆抗体。在免疫组织化学染色和免疫印迹实验中能识别SFRP1。
用法
免疫印迹:0.2-2µg/mL;1:500-5000
免疫组织化学:5-20µg/mL;1:50-200
免疫细胞化学:5-20µg/mL;1:50-200
最佳稀释倍数最终由用户决定。
储存
经常使用则4°C保存。-20°C保存不超过两年。避免反复冻融。
稳定性
热稳定性以损失率显示。损失率是由加速降解试验决定,具体方法如下:在37°C孵育48小时,没有显著的降解或者沉淀产生。保质期内,在适当的条件下存储,损失率低于5%。
赠品
增值服务
相关产品
| 编号 | 适用物种:Rattus norvegicus (Rat,大鼠) | 应用(仅供研究使用,不用于临床诊断!) |
| APF880Ra01 | 分泌型卷曲相关蛋白1(SFRP1)活性蛋白 | Cell culture; Activity Assays. |
| RPF880Ra01 | 分泌型卷曲相关蛋白1(SFRP1)重组蛋白 | Positive Control; Immunogen; SDS-PAGE; WB. |
| PAF880Ra01 | 分泌型卷曲相关蛋白1(SFRP1)多克隆抗体 | WB; IHC; ICC; IP. |
| LAF880Ra71 | 分泌型卷曲相关蛋白1(SFRP1)多克隆抗体(生物素标记) | WB; IHC; ICC. |
| MAF880Ra24 | 分泌型卷曲相关蛋白1(SFRP1)单克隆抗体 | IHC |
| MAF880Ra22 | 分泌型卷曲相关蛋白1(SFRP1)单克隆抗体 | IHC |
| MAF880Ra25 | 分泌型卷曲相关蛋白1(SFRP1)单克隆抗体 | IHC |
| MAF880Ra23 | 分泌型卷曲相关蛋白1(SFRP1)单克隆抗体 | IHC; ICC/IF |
| MAF880Ra21 | 分泌型卷曲相关蛋白1(SFRP1)单克隆抗体 | WB; IHC; ICC; IP. |
| MAF880Ra27 | 分泌型卷曲相关蛋白1(SFRP1)单克隆抗体 | IHC |
| SEF880Ra | 分泌型卷曲相关蛋白1(SFRP1)检测试剂盒(酶联免疫吸附试验法) | Enzyme-linked immunosorbent assay for Antigen Detection. |
| LMF880Ra | 分泌型卷曲相关蛋白1(SFRP1)等多因子检测试剂盒(流式荧光发光法) | FLIA Kit for Antigen Detection. |
参考文献
| 杂志 | 参考文献 |
| BMC Musculoskeletal Disorders | Biomarkers and cytokines of bone turnover: extensive evaluation in a cohort of patients with ankylosing spondylitis[PubMed: 23025387] |
| Exp Cell Res | Wnt Inhibition is Dysregulated in Gliomas and its Re-Establishment Inhibits Proliferation and Tumor Sphere Formation[PubMed: 26712519] |
| BMC Musculoskeletal Disorders | Correlation of blood bone turnover biomarkers and Wnt signaling antagonists with AS, DISH,OPLL, and OYL.[pubmed:28153008] |
| PloS one | Effects of exercise training on circulating levels of Dickkpof-1 and secreted frizzled-related protein-1 in breast cancer survivors: A pilot single-blind randomized controlled trial.[pubmed:28178355] |
| PLoS One | Effects of exercise training on circulating levels of Dickkpof-1 and secreted frizzled-related protein-1 in breast cancer survivors: A pilot single-blind randomized controlled trial[10.1371] |
| Journal of Experimental & Clinical Cancer Research | PHF21B overexpression promotes cancer stem cell-like traits in prostate cancer cells by activating the Wnt/β-catenin signaling pathway[pubmed:28645312] |
| JBMR Plus | Low serum levels of DKK2 predict incident low‐impact fracture in older women[Doi: 10.1002/jbm4.10179] |
| Nature Communications | Immunological history governs human stem cell memory CD4 heterogeneity via the Wnt signaling pathway[Pubmed: 32041953] |
| acta pharmacologica sinica | sFRP1 protects H9c2 cardiac myoblasts from doxorubicin-induced apoptosis by inhibiting the Wnt/PCP-JNK pathway[Pubmed: 32238888] |